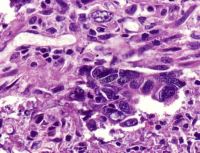

更多
相关文章
疾病简介
结合临床内镜下黏膜切除术(EMR)和内镜黏膜下剥离术(ESD)进行消化道早期癌的诊断;开展免疫组化进行结直肠癌的微卫星不稳定性(MSI)检测,为结直肠癌患者的预后和化疗药物的选择提供参考;开展结直肠癌KRAS基因突变检测,为患者基因靶向治疗提供依据。
结合临床内镜下黏膜切除术(EMR)和内镜黏膜下剥离术(ESD)进行消化道早期癌的诊断;开展免疫组化进行结直肠癌的微卫星不稳定性(MSI)检测,为结直肠癌患者的预后和化疗药物的选择提供参考;开展结直肠癌KRAS基因突变检测,为患者基因靶向治疗提供依据。
结合临床内镜下黏膜切除术(EMR)和内镜黏膜下剥离术(ESD)进行消化道早期癌的诊断;开展免疫组化进行结直肠癌的微卫星不稳定性(MSI)检测,为结直肠癌患者的预后和化疗药物的选择提供参考;开展结直肠癌KRAS基因突变检测,为患者基因靶向治疗提供依据。
相关科室
山东省立医院病理科创建于1957年。历经六十多年的积淀和发展,已形成一支技术精湛、专业完备的医疗团队,成为集医疗、教学、科研为一体的大型综合性病理诊断中心,系山东省省级临床重点专科,济南市智慧病理与肿瘤分子病理重点实验室。科室现有70名工作人员,含主任医师8人,副主任医师13人,主治医师3人,住院医师11人,副主任技师1人及主管技师12人,其中博士31人,硕士8人,拥有博士研究生导师1人,硕士研究生导师11人。科室全面推行亚专科建设,多人在国内外著名医学中心进修和深造。目前已形成消化、呼吸、乳腺、女性生殖、神经、淋巴造血、骨关节与软组织、泌尿男性生殖、分子病理、人… [详细]
版权所有:伟德1949官方网站
Copyrights © 2022 qdbpt.com All Rights Reserved联系电话:0531-87938911
ICP备案:鲁ICP备11002409号